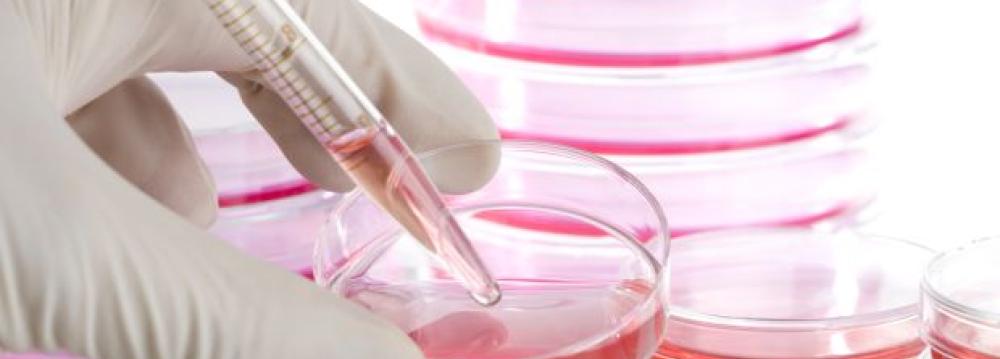

A research team led by Iranian researcher Ali Khademhosseini at the Massachusetts Institute of Technology, has managed to grow artificial heart, liver, and skin tissues. “These tissues, produced from stem cells, can be used in transplants,” Khademhosseini told Mehr News Agency. The goal of tissue engineering is to assemble functional constructs that restore, maintain, or improve damaged tissues or whole organs. “We have successfully tested the tissues in surgeries involving pigs and mice,” he added. A professor at Harvard University and the joint Harvard-MIT Division of Health Sciences and Technology (HST), Khademhosseini leads a large interdisciplinary team of over 90 researchers. His research is based on engineering biomaterials to enable regenerative medicine and the next generation of medical devices. He is also developing organ on chip systems that aim to mimic human response to various chemicals for drug discovery applications.